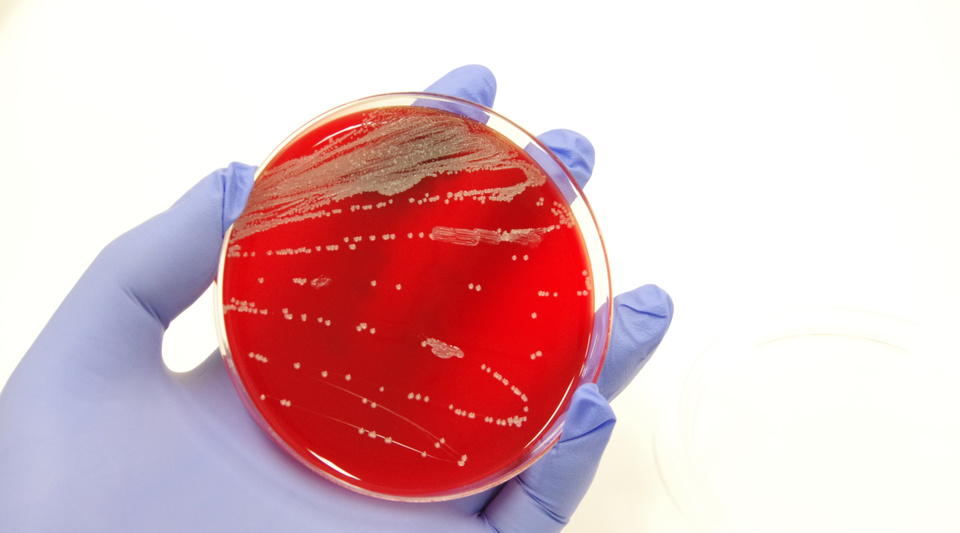
カビ毒分析用シャーレ

OMICの各ラボでは多様な分析サービスを提供しています。
*各サービスの写真をクリックすると、詳細ページに移動します。
残留農薬
GC-MS/MSやLC-MS/MSなどの最新の機器を導入しており、「多成分一斉分析法」と「個別分析法」の両方に対応し、穀物、野菜等農産物、加工品、飼料などを対象に600項目以上におよぶ残留農薬の分析サービスを提供しています。
重金属及びミネラル
金属には、健康を害する恐れのあるものがあり、毒性が強く蓄積性のある重金属類(鉛,カドミウム,ヒ素,水銀など)には、食品衛生法に規格が定められています。OMICではこれら重金属類やミネラルの分析サービスを提供しています。
遺伝子組換え(GMO)
様々な遺伝子組換え作物(GMO:Genetically Modified Organisms)を対象に、ELISA法やPCR法を用いた定性試験(遺伝子組換え作物が混入しているかどうか)及び定量試験(遺伝子組換え作物の混入率の測定)サービスを提供しています。
食品成分分析
一般に販売される加工食品等には栄養表示基準に基づく表示が必要で、また、商品取引きにおいても成分分析が要求されます。OMICでは、たん白質、脂肪、繊維分な一般成分等の幅広い食品分析サービスを提供しています。